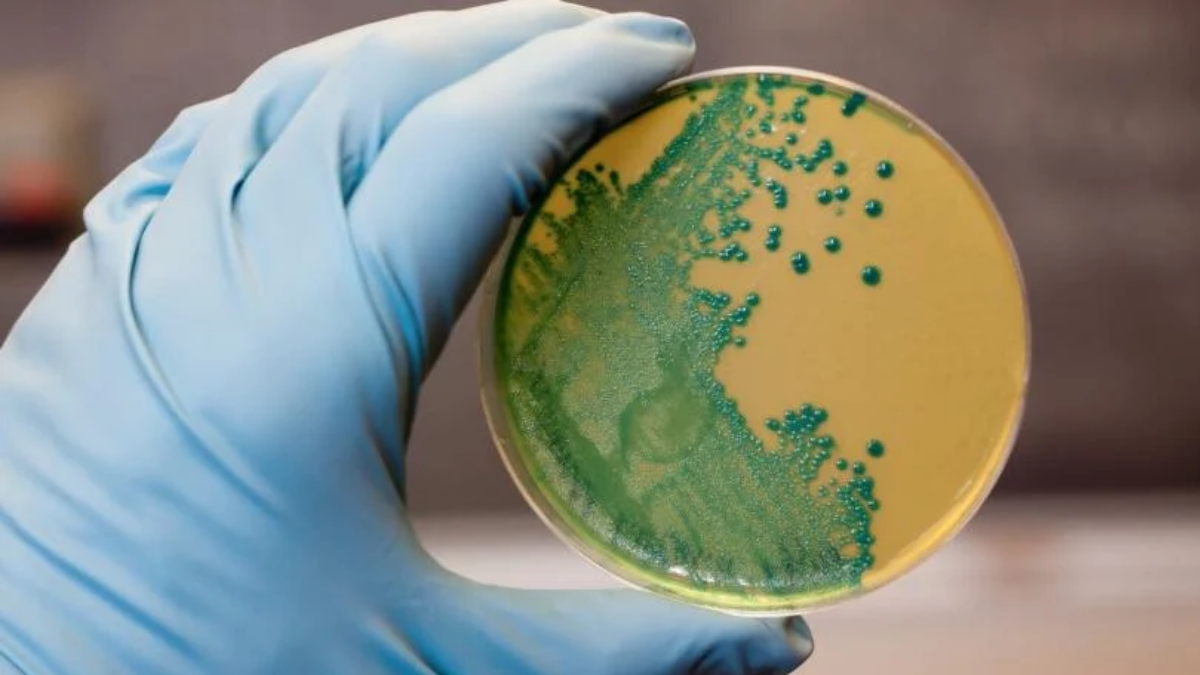
03-listeria

In a concerning development, a Listeria monocytogenes outbreak has swept through parts of the United States, prompting a widespread recall of ready-to-eat sandwiches and snack items. The contaminated products, produced by Fresh & Ready Foods LLC, have been linked to ten hospitalisations, mostly in California and Nevada, according to the Centers for Disease Control and Prevention (CDC). The outbreak, which dates back to December 2023, was only recently connected to specific food items, raising questions about how long contaminated products may have been in circulation.
Table of Content:-
Widespread Recall: What Products Are Affected?
The recall includes over 80 ready-to-eat products that were distributed to retailers, hospitals, hotels, airports, and airlines across California, Arizona, Nevada, and Washington. The affected products were sold between April 18 and April 25, with “Use By” dates ranging from April 22 to May 19. Consumers are urged to look for items sold under these brand names:

- Fresh & Ready Foods
- City Point
- Market Fresh Food to Go
- Fresh Take
- Crave Away
If you’ve purchased any of these items, authorities advise immediate disposal or returning the product to the point of sale. In addition, it’s important to thoroughly disinfect any containers or surfaces that came into contact with these foods to prevent further contamination.
Also Read: Just 5 Minutes Of Junk Food Ads Can Trigger Kids To Consume More Calories Daily, Study Finds
What Is Listeria and Why Is It Dangerous?
Listeria monocytogenes is a hardy bacterium found in soil, water, and decomposing organic material. What makes Listeria particularly dangerous is its ability to thrive in cold environments, including refrigerators—a place where most bacteria typically die off or stop growing.
Listeria is often spread through contaminated food, especially ready-to-eat products that aren’t reheated before consumption. Once it enters a food processing environment, the bacteria can persist for years, making it extremely difficult to eliminate without aggressive sanitation measures.
Symptoms and Who’s at Risk
Listeriosis, the infection caused by Listeria, can present a range of symptoms that vary depending on a person’s immune status and age. The most common signs include:
Also Read: Cancer-Linked Chemicals Detected In Widely Used Skincare and Makeup Products: Study
- Fever and chills
- Muscle aches
- Nausea or vomiting
- Diarrhoea
- Headache and confusion
- Stiff neck and imbalance
In more severe cases, Listeria infection can lead to meningitis, bloodstream infections, and even death. The CDC estimates that 1,600 people are infected annually in the U.S., and around 260 die as a result. The most vulnerable groups include infants, elderly individuals, pregnant women, and those with weakened immune systems.
One of the most alarming aspects of Listeria is its long incubation period. Symptoms can appear within a few hours, but in some cases, it can take up to three months after consumption of contaminated food for symptoms to develop—complicating diagnosis and treatment efforts.
Is Listeria Preventable?
Yes—Listeria can be destroyed by cooking food to at least 165°F (74°C). However, since many of the recalled products were intended to be eaten cold, heating isn’t a viable safety measure in this case. To reduce the risk of contamination in the future, health authorities recommend:
- Cleaning and disinfecting refrigerators regularly
- Washing hands and kitchen surfaces after handling potentially contaminated foods
- Staying informed about recalls from trusted sources like the CDC or FDA
Bottomline
While Fresh & Ready Foods LLC has voluntarily initiated the recall, the outbreak serves as a stark reminder of the hidden risks in everyday food items, especially those not cooked before consumption. Consumers are urged to check their fridges and stay vigilant for any symptoms if they’ve consumed the recalled products. Prompt action can prevent further illness and ensure contaminated items are kept off the shelves—and more importantly, off our plates.
Also watch this video
How we keep this article up to date:
We work with experts and keep a close eye on the latest in health and wellness. Whenever there is a new research or helpful information, we update our articles with accurate and useful advice.
Current Version